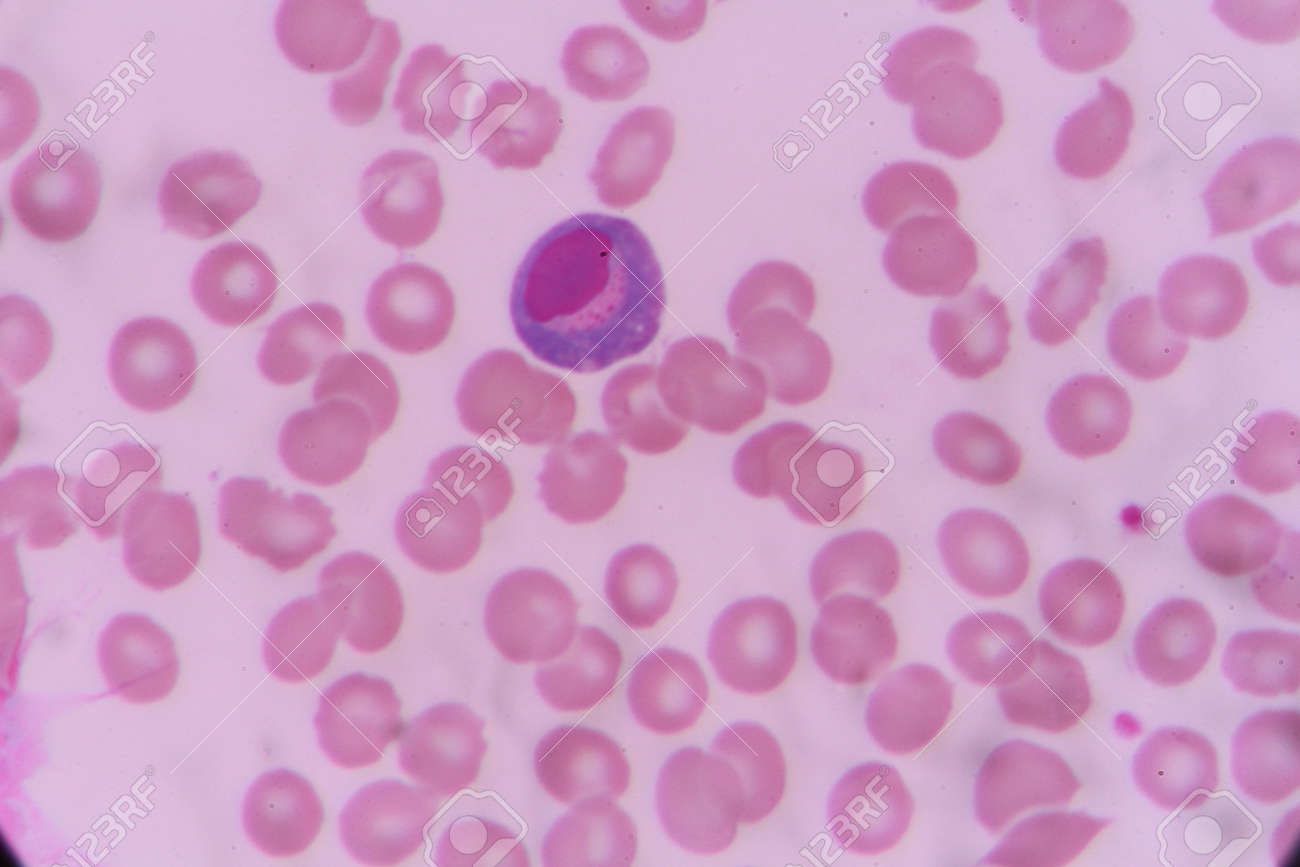
etiam-dictum-ipsum-a-felis

Download
Close
Автор:
id:
Ключевые слова:
atypical, atypical lymphocyte, basophil, blood, cbc, cell, cells, diagnosis, disease, eosinophil, fever, health, hematology, human, infection, lab, laboratory, leukemia, lymphocyte, medical, medicine, microscope, neutrophil, red, smear, white,





